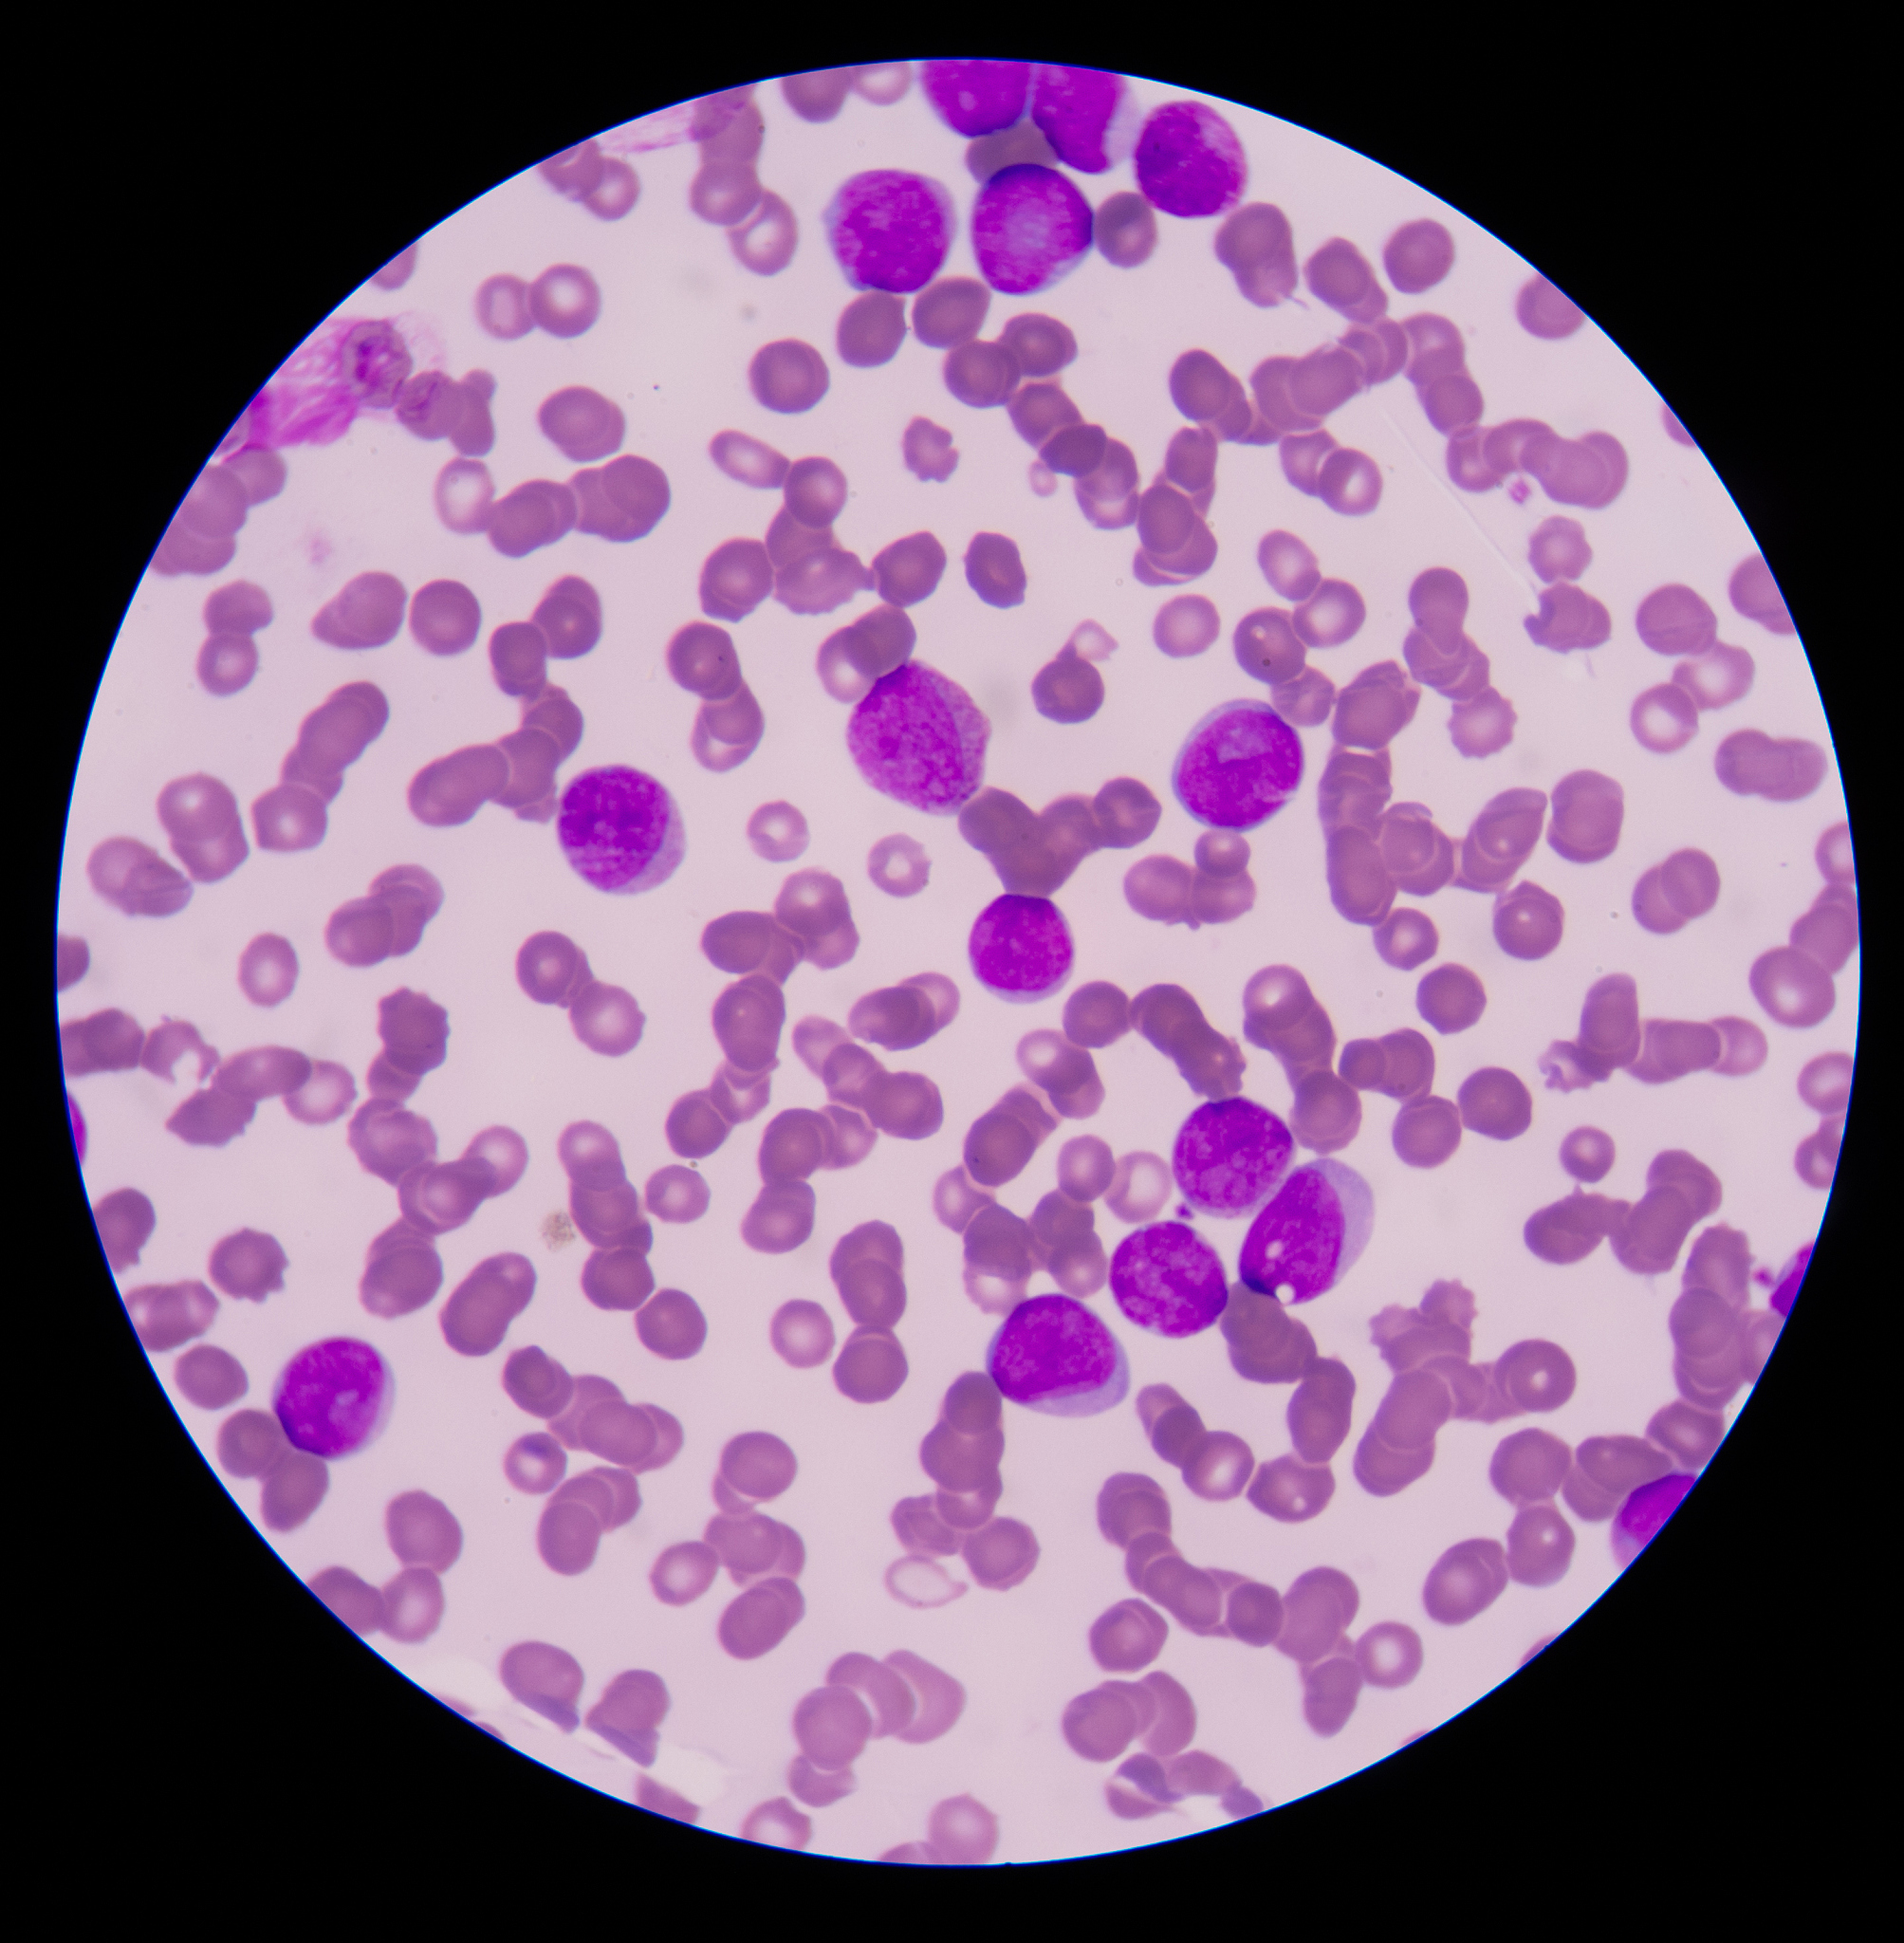
人血血红蛋白正常值范围：男女、儿童和新生儿

人血血红蛋白正常值范围:男女、儿童和新生儿
根据不同的年龄和性别,人血血红蛋白计数正常范围略有差异,但一般情况下为:
男性:13.5-17.5 g/dL(克/分升)
女性:12.0-15.5 g/dL(克/分升)
新生儿:14.0-20.0 g/dL(克/分升)
儿童:11.5-15.5 g/dL(克/分升)
这些值是在正常生理状态下测量的,如果出现异常情况,如贫血或失血等,血红蛋白计数可能会下降。
原文地址: https://www.cveoy.top/t/topic/op2c 著作权归作者所有。请勿转载和采集!